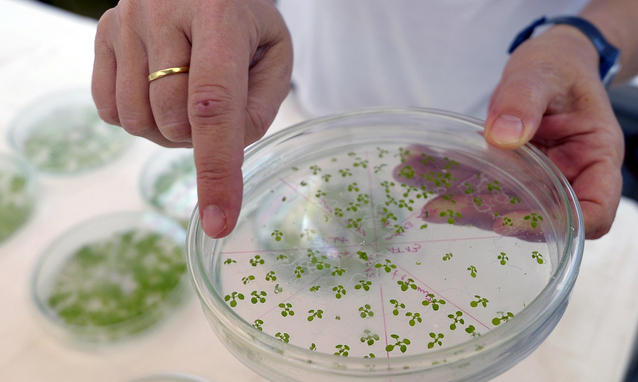

Due giorni fa sul Corriere Nunzia de Girolamo, avvocato e ministro dell’agricoltura, sosteneva che «gli OGM non sono utili all’Italia. La nostra è un’agricoltura d’eccellenza sana e pulita». Sull’utilità degli OGM per l’agricoltura italiana, i dati della FAO come quelli ufficiali del ministero raccontano un’altra storia. Dicono che non solo sono utili, essi sono necessari, perché importiamo 4 milioni di tonnellate ogni anno di soia transgenica e derivati dall’America Latina, che rendono possibile le produzioni alimentari di cui andiamo fieri, a cominciare dal Parmigiano. Queste importazioni servono infatti a sfamare milioni di animali (mucche, maiali, polli…) che alleviamo in Italia e che sono cruciali per fare carne, latte e formaggi. Il ministro ha annunciato che farà una norma per vietare la coltivazione di OGM in Italia.
La posizione del ministro trasuda disprezzo per la normativa comunitaria (che, ci piaccia o no, è quella che conta), per il contribuente (espone l’Italia all’ennesima procedura d’infrazione), per la comunità scientifica competente (a cui è impedito fare prove di campo da 10 anni e che, da molti anni, ha ribadito, compatta, la sicurezza dei prodotti transgenici per il consumo e la coltivazione), ed infine per gli agricoltori (a cui impedisce di coltivare cose che comunque importiamo). Ecco allora alcune domande che vorrei porre a tutti. Può un ministro dire che farà una cosa illegale lasciando poi che i cittadini paghino le conseguenze di un tale atto? E poi chiedere l’osservanza della legge e il pagamento delle tasse? Fino a che punto è possibile mantenere un sistema di menzogna che disprezza la realtà giuridica, scientifica e quella, impietosa, della bilancia agroalimentare, sperando solo in un facile consenso? Non è questa una ricetta per il disastro di una nazione?.

L’Associazione Luca Coscioni è una associazione no profit di promozione sociale. Tra le sue priorità vi sono l’affermazione delle libertà civili e i diritti umani, in particolare quello alla scienza, l’assistenza personale autogestita, l’abbattimento della barriere architettoniche, le scelte di fine vita, la legalizzazione dell’eutanasia, l’accesso ai cannabinoidi medici e il monitoraggio mondiale di leggi e politiche in materia di scienza e auto-determinazione.